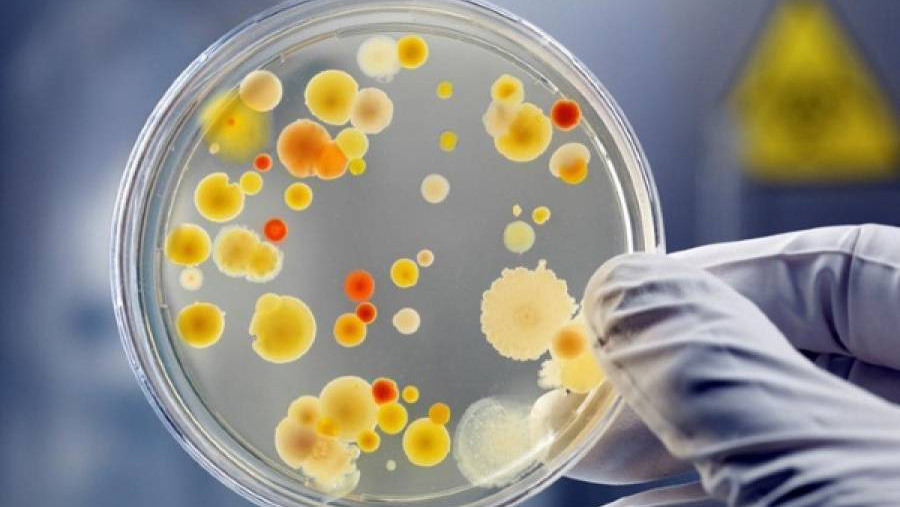
Інформує Лубенський підрозділ ДУ «Полтавський обласний центр контролю та профілактики хвороб"

Слава Україні! Розпочалась 980-та доба широкомасштабної збройної агресії російської федерації проти України.
Загалом, протягом минулої доби зафіксовано 175 бойових зіткнень. За уточненою інформацією, вчора противник завдав по позиціях українських підрозділів та населених пунктах три ракетних удари із застосуванням трьох ракет, а також 77 авіаударів, зокрема, скинув 156 КАБ. Крім цього, здійснив понад 4750 обстрілів, з них 148 - із реактивних систем залпового вогню, та задіяв для уражень близько 1400 дронів-камікадзе. Агресор завдавав авіаударів, зокрема в районах населених пунктів Марчихина Буда, Микільське, Нова Січ, Харків, Вовчанськ, Гоптівка, Надія, Лиман, Сіверськ, Різниківка, Никифорівка, Олександропіль, Мирноград, Ганнівка, Успенівка, Роздольне, Велика Новосілка, Новодарівка, Олександро-Шультине, Плещіївка, Олексієво-Дружківка, Сухі Яли, Білогір’я, Новоандріївка, Львове. Вчора авіація та ракетні війська і артилерія Сил оборони завдали одинадцять ударів по районах зосередження особового складу і ОВТ противника, знищено одну артилерійську систему та дві інші важливі цілі противника. На Харківському напрямку відбулося чотири ворожих атаки в районах населених пунктів Вовчанськ та Липці. Триває операція у Курській області.
Наші воїни завдають окупаційним військам відчутних втрат в живій силі, техніці і активно підривають наступальний потенціал ворога у тилу. Загалом, минулої доби втрати російських загарбників склали 1560 осіб. Також українські воїни знешкодили 8 танків, 29 бойових броньованих машин, 38 артилерійських систем, реактивну систему залпового вогню, 2 засоби ППО, 40 БпЛА оперативно-тактичного рівня, 91 одиницю автомобільної та одиницю спеціальної техніки окупантів.